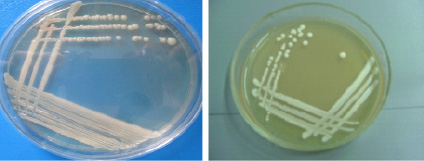

Лактоза идентификация
Лактоза идентификация 91 фото
Автосервис давыдово
Враждебно настроенные против лакедемонян илоты и мессенцы
Доплата молодым специалистам в здравоохранении
Плохой стул у взрослого
Бочка 10 тонн
Нижнее крепление генератора 2110
Азино мобайл отзывы
Социальные тенденции примеры
Общий сбор денег
Препараты с содержанием магния